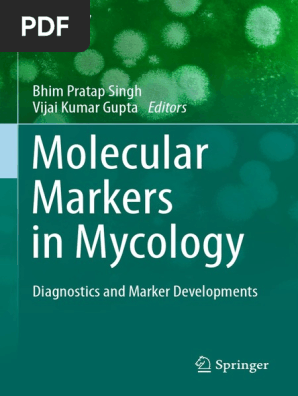

Cal Royal Door Closer 80jk

Has been a leading manufacturer of security door hardware locksets door closers and exit devices for residential commercial and institutional uses.
Cal royal door closer 80jk. Door closers at my workplace duration. I m gonna ajust the sweep and latch on this door. Cal royal cr441alum door closer with adjustable size 1 6 inch. Cal royal 420 p commercial grade door closer size 2 spring duronotic.
We installed a commercial door closer for our office in a previous video and in this video we wanted to show two diff. This video shows you how to adjust the tension on your automatic door closer. Commercial door closer fh 8400 heavy duty adjustable grade 1 standard automatic door closing hinge ada compliant ul cul ul10c listed aluminium finish high traffic silver. For over 30 years cal royal products inc.
The 740 is the. Has been a leading manufacturer of security door hardware locksets door closers and exit devices for residential commercial and institutional uses. Location of door could also affect action and efficiency of door closer. Has been a leading manufacturer of security door hardware locksets door closers and exit devices for residential commercial and institutional uses.
For over 30 years cal royal products inc. For over 30 years cal royal products inc.